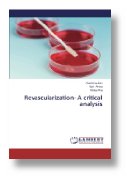

|
Tissue Regeneration in Endodontics: An Emerging Field in the Modern Era
(1st Edition Paperback)
Sandeep Kothamachu BDS MDS, Pradnya Nikhade BDS MDS and Manoj Chandak BDS MDS
Release date: October 17, 2012
$63.00

FREE SHIPPING!
5 New from $54.48 1 Used from $74.58
|
|
|
|
|

|
Internal Complexity of Tooth: Internal Tooth Anatomy
(1st Edition Paperback)
Vandana Bhardwaj BDS MDS
Release date: October 13, 2012
List Price: $75.00
$71.49
You Save $3.51 (5%)

FREE SHIPPING!
5 New from $65.07 1 Used from $87.27
|
|
|
|
|

|
Adhesive Dental Materials for Reinforcing Weakened Root Structure
(1st Edition Paperback)
Ahmed Mahmood Ahmed BDS MSc FRACDS, Adam Husein BDS Grad Dip Clin Dent Doc Clin Dent FRACDS and Wan Zaripah Wan Bakar BDS GradDipClinDent DClinDent FRACDS
Release date: December 19, 2012
List Price: $78.00
$71.47
You Save $6.53 (8%)

FREE SHIPPING!
11 New from $64.94 3 Used from $88.80
|
|
|
|
|

|
Calcium Hydroxide as an Intra-Canal Medicament
(1st Edition Paperback)
Sultan Omer Sheriff BDS MDS
Release date: January 29, 2013
$66.00

FREE SHIPPING!
11 New from $54.25 1 Used from $75.32
|
|
|
|
|

|
Coronal Seal in Endodontically Treated Teeth
(1st Edition Paperback)
Shahbaz Ahmed BDS MSc (UK) FCPS (Pak)
Release date: January 24, 2013
List Price: $65.00
$50.52
You Save $14.48 (22%)
9 New from $50.52 1 Used from $74.20
|
|
|
|
|

|
Effect of Sodium Hypochlorite on Dentine Edge Strength
(1st Edition Paperback)
Shahbaz Ahmed BDS MSc (UK) FCPS (Pak)
Release date: January 18, 2013
$65.00

FREE SHIPPING!
10 New from $54.03 2 Used from $74.20
|
|
|
|
|

|
Gutta Percha: All You Need to Know
(1st Edition Paperback)
Shreya Hegde BDS MDS, Amit Yadav BDS MDS and Harish Shetty BDS MDS
Release date: January 29, 2014
List Price: $61.00
$60.29
You Save $0.71 (1%)

FREE SHIPPING!
11 New from $52.07 3 Used from $69.70
|
|
|
|
|

|
Regeneration in Endodontics: Anthology of Research
(1st Edition Paperback)
Urvashi Bhanwal BDS MDS, Roopa R. Nadig BDS MDS and Karthik J. BDS MDS
Release date: January 24, 2014
List Price: $68.00
$66.34
You Save $1.66 (2%)

FREE SHIPPING!
11 New from $59.81 3 Used from $77.57
|
|
|
|
|

|
Regenerative Endodontics - A Paradigm Shift
(1st Edition Paperback)
Bobbin Gill BDS MDS, Jaidev Singh Dhillon BDS MDS and Amita Saini BDS
Release date: December 20, 2013
List Price: $89.00
$86.56
You Save $2.44 (3%)

FREE SHIPPING!
10 New from $80.04 5 Used from $99.23
|
|
|
|
|
|
Revascularization - A Critical Analysis
(1st Edition Paperback)
Akanksha Jain BDS, Vipin Arora BDS MDS and Shalya Raj BDS MDS
Release date: November 18, 2014
$62.00

FREE SHIPPING!
10 New from $57.99 2 Used from $70.83
|
|
|
|
|
| < 17 18 19 20 21 > Pages: 22 |